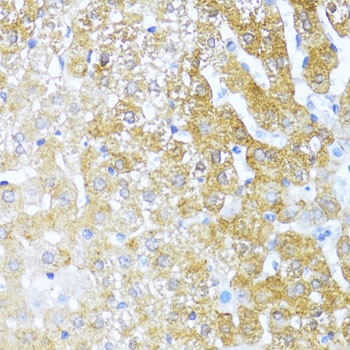
产品细节图片2
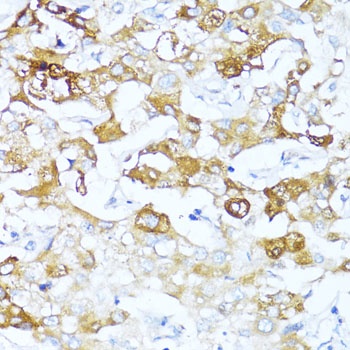
产品细节图片4

相关产品推荐更多 >
万千商家帮你免费找货
0 人在求购买到急需产品
- 详细信息
- 文献和实验
- 技术资料
- 抗体名:
SERPINA3 Antibody抗体
- 抗体英文名:
SERPINA3 Antibody
- 靶点:
SERPINA3
- 浓度:
batch dependent
- 应用范围:
IF, IHC, WB
- 适应物种:
Human, Mouse, Rat
- 保质期:
6-12个月
- 抗原来源:
详询
- 目录编号:
orb1258049
- 级别:
科研级
- 库存:
88
- 供应商:
biorbyt
- 标记物:
Unconjugated
- 克隆性:
Polyclonal
- 形态:
Liquid
- 亚型:
IgG
- 免疫原:
Recombinant fusion protein containing a sequence corresponding to amino acids 24-423 of human SERPINA3 (NP_001076.2).
- 规格:
100 ul
别名:Alpha-1-antichymotrypsin, ACT, Cell growth-inhibiting gene 24/25 protein, Serpin A3, Alpha-1-antichymotrypsin His-Pro-less, SERPINA3, AACT
免疫原:Recombinant fusion protein containing a sequence corresponding to amino acids 24-423 of human SERPINA3 (NP_001076.2).
分子量:Observed: 48kDa
应用注释:WB: 1:200 - 1:1000IHC: 1:50 - 1:200IF: 1:50 - 1:200
防腐剂:Liquid
纯化:Affinity 纯化
保存说明:Maintain refrigerated at 2-8°C for up to 2 weeks. For long term storage store at -20°C in small aliquots to prevent freeze-thaw cycles.
UniProt ID:P01011
Note:For research use only.

风险提示:丁香通仅作为第三方平台,为商家信息发布提供平台空间。用户咨询产品时请注意保护个人信息及财产安全,合理判断,谨慎选购商品,商家和用户对交易行为负责。对于医疗器械类产品,请先查证核实企业经营资质和医疗器械产品注册证情况。
文献和实验浅谈 RNA 测序:从阿尔茨海默症相关星形胶质细胞的发现说起
中共染色 GFAP、SERINA3N 和 VIM(分别是反应性星形胶质细胞和神经干细胞的标记),验证了 DAA 在蛋白质水平上的存在并表征了它们的空间分布(图 1e,1f)。在 5xFAD 小鼠中观察到 GFAP+、 SERPINA3N+、 VIM+ 的星形胶质细胞,并且高度集中于下丘脑,但在 WT 小鼠中未观察到,这与 sNuc-seq 谱图一致。在野生型小鼠中,在齿状回中发现了 VIM+ 细胞,这也与已知的结论相一致。图 1. DAA 与多种分子途径相关,AD 模型中位于 Aβ 斑块附近图片
全球范围内,心血管疾病与癌症死亡率分别占居民疾病死亡总数的 32% 和 26%。许多心衰患者死于非心血管疾病,包括癌症。多项临床流行病学和前瞻性队列研究发现,与未患心血管疾病的人群相比,心血管疾病患者罹患癌症的风险更高;携带较多心血管疾病风险因素的人群患癌风险也更高。已有研究表明,心衰加速肿瘤生长,心衰促进肿瘤生长可能与心脏分泌相关因子SerpinA3有关。 2023 年 3 月 27 日,哈尔滨医科大学药学院的杨宝峰院士/杜伟杰教授团队在 Signal Transduction
技术资料暂无技术资料 索取技术资料











